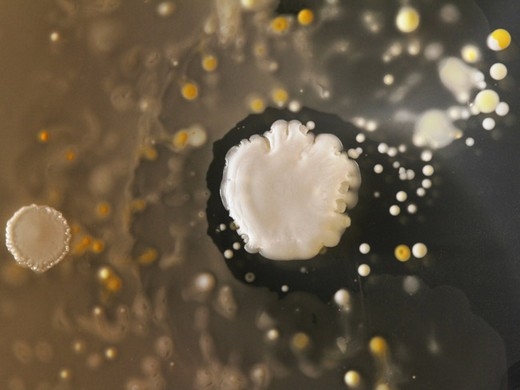

Bu Bakteriler Cep Telefonunda Yaşıyorlar
25 Temmuz 2015 Cumartesi 12:12Sanat çalışması gibi görünen bu fotograf aslında bir bakteriye ait.
Tüm Hakları Saklıdır © 2014 Haberdarım | İzinsiz ve kaynak gösterilmeden yayınlanamaz.
Haber Yazılımı: So Bilişim
Haber Yazılımı: So Bilişim